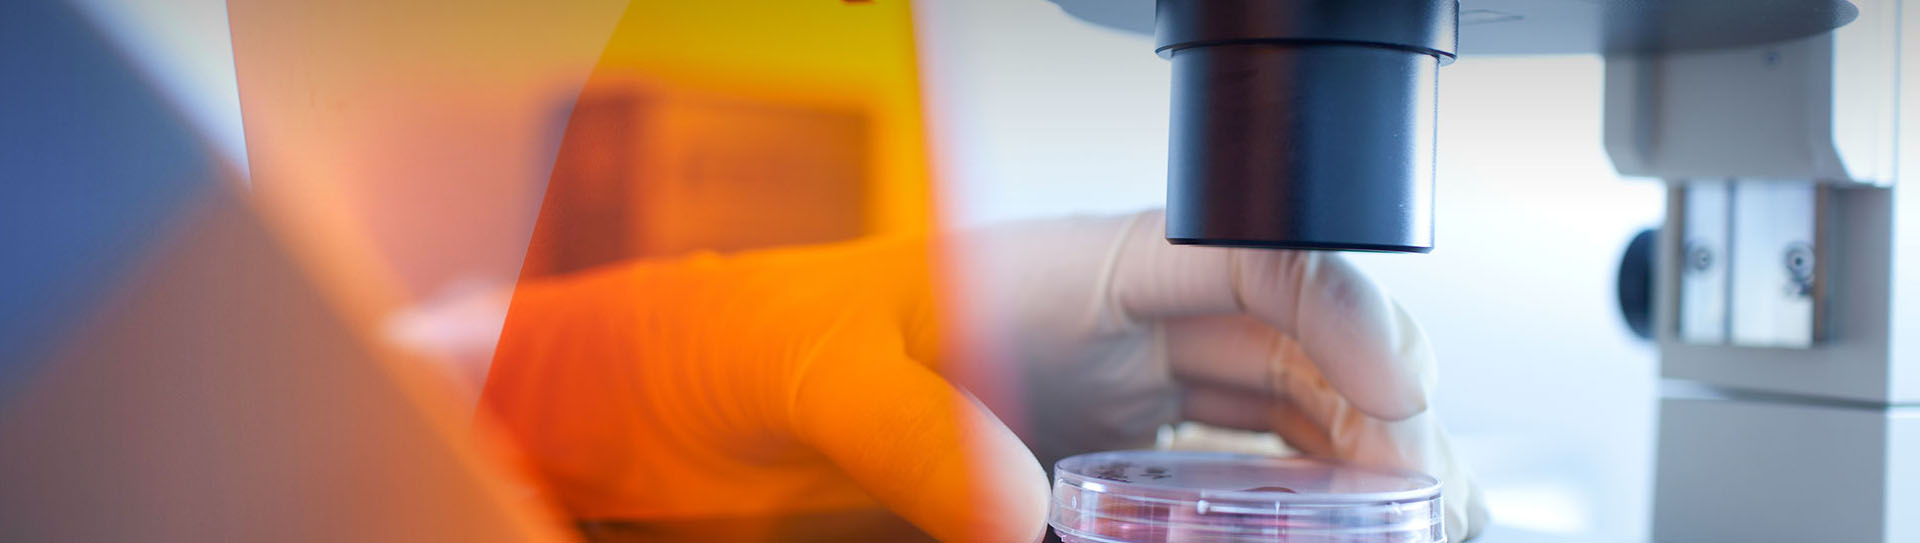

公司簡介
企業榮譽
企業風貌
二氟系列
三氟系列
其他產品
中文版
English
日本語
???
Deutsch
Русский
Espa?ol
公司簡介
企業榮譽
企業風貌
二氟系列
三氟系列
其他產品
中文版
English
日本語
???
Deutsch
Русский
Espa?ol

南通寶凱藥業有限公司成立于2006年,注冊資本2500萬元。公司位于江蘇省啟東市北新鎮啟東生命健康產業園,占地46畝,是一家集科研、開發、生產和銷售為一體的科技型企業。公司與浙江大學、浙江科技學院、德國艾姆登-雷爾(Emden-Leer)等大學建立了長期緊密的合作關系,具備強大的研發力量,全部產品均擁有自主知識產權。公司已成功開發并生產系列含氟精細化學品如三氟乙酸系列、二氟乙酸系列、二氟溴乙酸系列和二氟氯乙酸系列等。
公司已取得ISO9001:2015質量管理體系認證、ISO14000:2015環境質量管理體系認證、ISO45001: 2018職業健康安全管理體系認證證書,并通過省級安全標準化達標評審。多年來,本公司與多家世界知名企業建立了業務往來。以科技創新、環境友好、高效節能、質量第一的生產理念,以誠信務實、開拓進取、合作共贏、追求卓越的企業精神,公司致力與大家共創美好未來。

地 址:啟東市北新鎮啟東生命健康產業園 郵 箱:sales@baokaichem.com
聯系人:孫先生(15068135816)/ 梁小姐 電 話:0513-83886111 傳 真:0513-83889158
